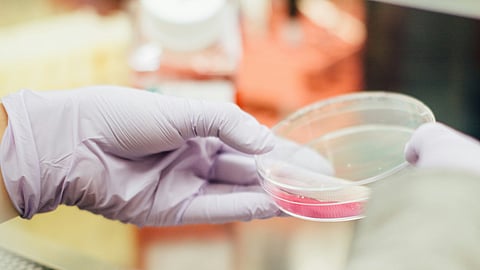
HIV weakens the body and can lead to a condition known as AIDS (Representational image: Unsplash)

HIV treatment drug Lenacapavir, sold by US pharmaceutical giant Gilead under the brand of Sunlenca could cost as little as $40 a year per patient, a whopping thousand times less than its current price of over $42,000, The Guardian reported on Tuesday citing a new research study.
The drug hailed as ‘the closest we have ever been to an HIV vaccine’ is currently sold by the US pharma giant at Rs $42,250 for the first year.
HIV, or Human Immunodeficiency Virus, is a virus that weakens the body’s immune system and can lead to a condition called AIDS (Acquired Immunodeficiency Syndrome). The virus is caused due to sexual contact, shared needles, and contact with infected blood.
The dose comes in the form of oral tablets and injections for HIV therapy, followed by injections every six months to sustain the treatment.
Last month, Gilead announced the test results of Lenacapavir, which showed that it offered 100 per cent protection during a trial conducted on 5,000 women in South Africa and Uganda
Organisations including UNAids have urged the company to make it available globally at an affordable price.
A study presented at the 25th International Aids conference in Munich on Tuesday suggested that after considering the ingredients and manufacturing costs of Lenacapavir, it is estimated that its generic version, if mass-produced, could cost as low as $40 a year and still generate 30 per cent profit.
This cost is based on the idea of assuming that 10 million people would use the drug annually.
The drug is currently licensed for only treatment, not prevention. The Munich conference study estimates that in the longer run, around 60 million people would require taking the drug preventatively to lower HIV levels significantly.
According to the World Health Organisation, 39.9 million people were living with HIV worldwide at the end of 2023.
In Africa, one in every 25 adults is living with HIV.
WHO
In India, 2,500,000 adults and children were living with HIV infection at the end of 2023, UNAids estimates. India HIV Estimates 2021 report says that AIDS-related deaths were around 42,000 in India in 2021.
(Input from various sources)
(Rehash/ Simran Sethi/MSM)